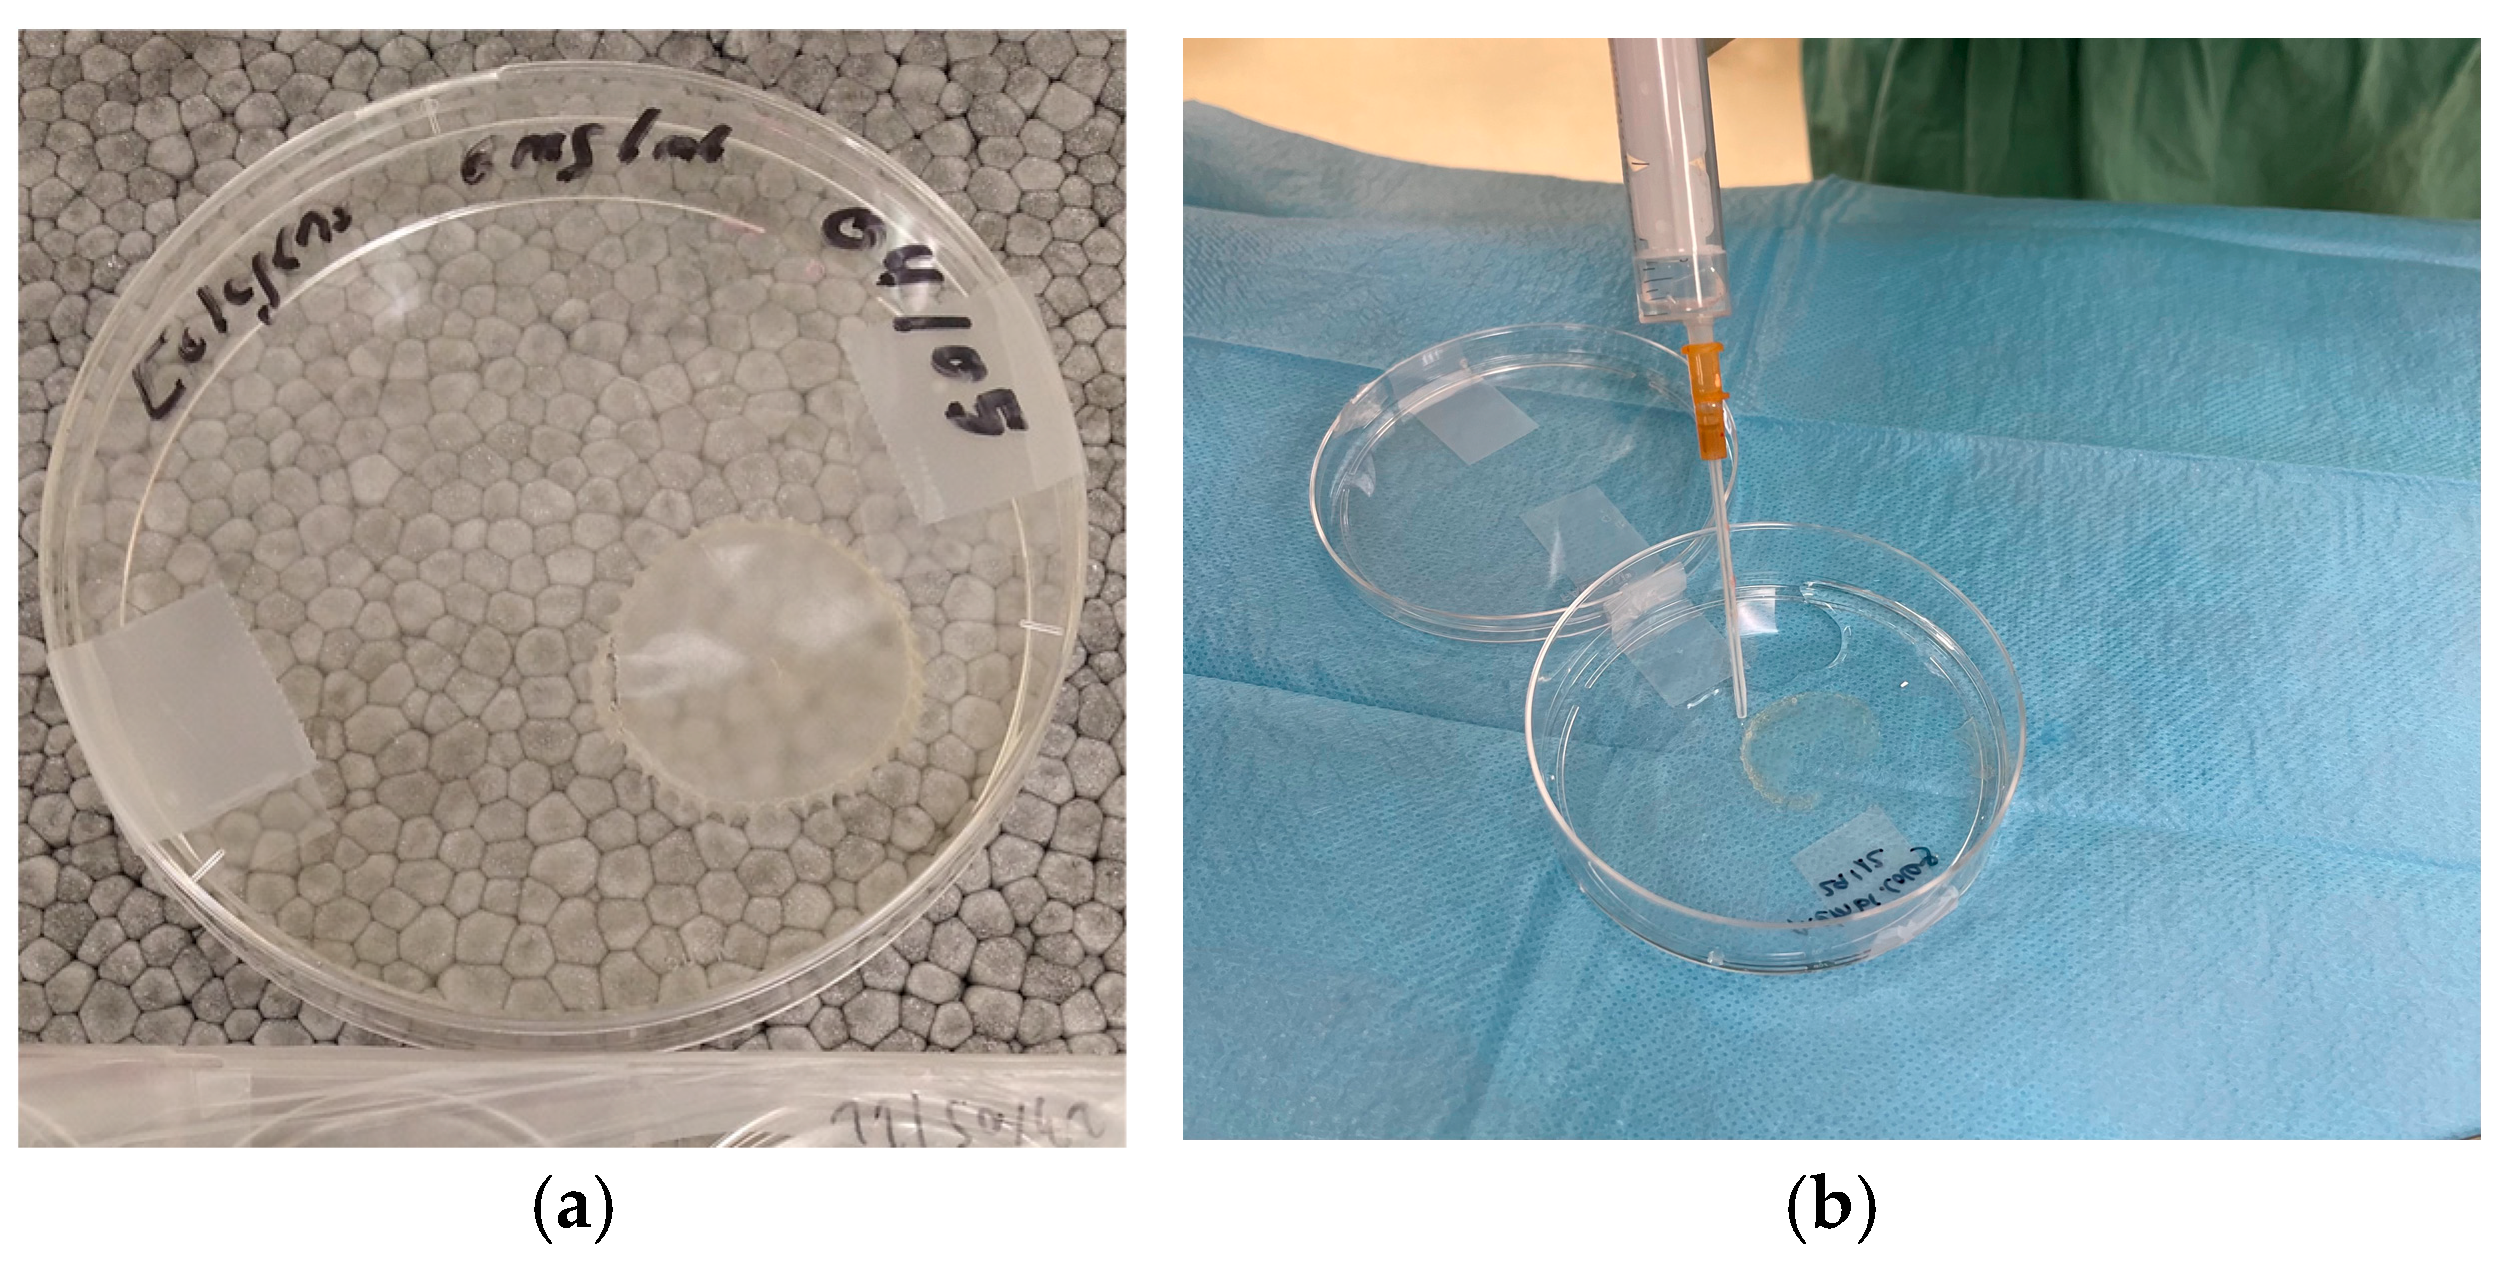

From Waste to Innovation: A Circular Economy Approach for Tissue Engineering by Transforming Human Bone Waste into Novel Collagen Membranes
Abstract
1. Introduction
2. Materials and Methods
2.1. Isolation and Production of Collagen I Membranes
2.2. Morphological Analysis
2.3. Mechanical Properties Analysis
2.4. In Vivo Experiments
2.5. Computed Tomography (CT) and Micro-CT Analyses (μCT)
2.6. Histological Examination
2.7. Statistical Analysis
3. Results
3.1. Morphological Observation
3.2. Mechanical Properties
3.3. Radiological and Micro-CT Analyses (μCT)
3.4. Histological Observation
4. Discussion
5. Conclusions
Author Contributions
Funding
Institutional Review Board Statement
Informed Consent Statement
Data Availability Statement
Acknowledgments
Conflicts of Interest
References
- Manyalich, M.; Navarro, A.; Koller, J.; Loty, B.; De Guerra, A.; Cornu, O.; Vabels, G.; Fornasari, P.M.; Costa, A.N.; Siska, I.; et al. European Quality System for Tissue Banking. Transplant. Proc. 2009, 41, 2035–2043. [Google Scholar] [CrossRef] [PubMed]
- Organización Nacional de Trasplantes; Asociación Española de Bancos de Tejidos Plan Estratégico Nacional de Tejidos 2022-2026. 2022. Available online: https://www.ont.es/wp-content/uploads/2023/06/PLAN-ESTRATEGICO-NACIONAL-DE-TEJIDOS-2022-2026-Abril-2022.pdf (accessed on 15 September 2024).
- Howkins, J. ReThinking the Creative Economy. 2022. Available online: https://www.academia.edu/82397309/ReThinking_the_Creative_Economy (accessed on 20 November 2024).
- Dziuba, R.; Kucharska, M.; Madej-Kiełbik, L.; Sulak, K.; Wiśniewska-Wrona, M. Biopolymers and Biomaterials for Special Applications within the Context of the Circular Economy. Materials 2021, 14, 7704. [Google Scholar] [CrossRef] [PubMed]
- Aguilar, A.; Twardowski, T.; Wohlgemuth, R. Bioeconomy for Sustainable Development. Biotechnol. J. 2019, 14, 1800638. [Google Scholar] [CrossRef] [PubMed]
- Duan, H.; Song, G.; Qu, S.; Dong, X.; Xu, M. Post-consumer packaging waste from express delivery in China. Resour. Conserv. Recycl. 2019, 144, 137–143. [Google Scholar] [CrossRef]
- Dahlin, C.; Linde, A.; Gottlow, J.; Nyman, S. Healing of Bone Defects by Guided Tissue Regeneration. Plast. Reconstr. Surg. 1988, 81, 672–676. [Google Scholar] [CrossRef]
- Ramos, E.U.; Leandro, M.N.C.; Criales, J.O.C.; Buitron, M.R.O.; Verástegui, E.S.; Carbajal, W.M.; Adrianzén, R.C.S.; Grijalva, A.E.E.; Baylon, A.A.B.; Bassi, A.P.F. Evaluation of Porcine Collagen Membranes Used with Guided Bone Regeneration for Critical Defects: A Histological, Histomorphometric, Immunohistochemical, and Inflammatory Profile Analysis. Eur. J. Dent. 2024, 18, 898–906. [Google Scholar] [CrossRef] [PubMed]
- Calciolari, E.; Ravanetti, F.; Strange, A.; Mardas, N.; Bozec, L.; Cacchioli, A.; Kostomitsopoulos, N.; Donos, N. Degradation pattern of a porcine collagen membrane in an in vivo model of guided bone regeneration. J. Periodontal Res. 2018, 53, 430–439. [Google Scholar] [CrossRef]
- Maurer, T.; Stoffel, M.H.; Belyaev, Y.; Stiefel, N.G.; Vidondo, B.; Küker, S.; Mogel, H.; Schäfer, B.; Balmer, J. Structural characterization of four different naturally occurring porcine collagen membranes suitable for medical applications. PLoS ONE 2018, 13, e0205027. [Google Scholar] [CrossRef]
- Cucchi, A.; Bettini, S.; Fiorino, A.; Maglio, M.; Marchiori, G.; Corinaldesi, G.; Sartori, M. Histological and histomorphometric analysis of bone tissue using customized titanium meshes with or without resorbable membranes: A randomized clinical trial. Clin. Oral Implant. Res. 2024, 35, 114–130. [Google Scholar] [CrossRef]
- Gottlow, J.; Nyman, S.; Lindhe, J.; Karring, T.; Wennström, J. New attachment formation in the human periodontium by guided tissue regeneration Case reports. J. Clin. Periodontol. 1986, 13, 604–616. [Google Scholar] [CrossRef] [PubMed]
- Yang, Z.; Wu, C.; Shi, H.; Luo, X.; Sun, H.; Wang, Q.; Zhang, D. Advances in Barrier Membranes for Guided Bone Regeneration Techniques. Front. Bioeng. Biotechnol. 2022, 10, 921576. [Google Scholar] [CrossRef]
- Xiong, Y.-Z.; Gao, R.-N.; Zhang, H.; Dong, L.-L.; Li, J.-T.; Li, X. Rationally designed functionally graded porous Ti6Al4V scaffolds with high strength and toughness built via selective laser melting for load-bearing orthopedic applications. J. Mech. Behav. Biomed. Mater. 2020, 104, 103673. [Google Scholar] [CrossRef]
- Zhang, C.; Zhang, T.; Geng, T.; Wang, X.; Lin, K.; Wang, P. Dental Implants Loaded With Bioactive Agents Promote Osseointegration in Osteoporosis: A Review. Front. Bioeng. Biotechnol. 2021, 9, 591796. [Google Scholar] [CrossRef] [PubMed]
- Gallego, L.; Junquera, L.; García-Consuegra, L.; Martinez, A.; Meana, Á. Regeneration of Mandibular Osteoradionecrosis With Autologous Cross-Linked Serum Albumin Scaffold. Regen. Med. 2020, 15, 1841–1849. [Google Scholar] [CrossRef] [PubMed]
- Llorente, J.J.; Junquera, L.; Gallego, L.; Pérez-Basterrechea, M.; Suárez, L.I.; Llorente, S. Design, In Vitro Evaluation and In Vivo Biocompatibility of Additive Manufacturing Three-Dimensional Printing of β beta-Tricalcium Phosphate Scaffolds for Bone Regeneration. Biomedicines 2024, 12, 1049. [Google Scholar] [CrossRef] [PubMed]
- Zeng, J.-H.; Liu, S.-W.; Xiong, L.; Qiu, P.; Ding, L.-H.; Xiong, S.-L.; Li, J.-T.; Liao, X.-G.; Tang, Z.-M. Scaffolds for the repair of bone defects in clinical studies: A systematic review. J. Orthop. Surg. Res. 2018, 13, 33. [Google Scholar] [CrossRef] [PubMed]
- Oryan, A.; Alidadi, S.; Moshiri, A.; Maffulli, N. Bone regenerative medicine: Classic options, novel strategies, and future directions. J. Orthop. Surg. Res. 2014, 9, 18. [Google Scholar] [CrossRef] [PubMed]
- Nandi, S.K.; Roy, S.; Mukherjee, P.; Kundu, B.; De, D.K.; Basu, D. Orthopaedic applications of bone graft & graft substitutes: A review. Indian. J. Med. Res. 2010, 132, 15–30. [Google Scholar] [PubMed]
- Goldberg, V.M.; Stevenson, S. Natural history of autografts and allografts. Clin. Orthop. Relat. Res. 1987, 225, 7–16. [Google Scholar] [CrossRef]
- Younger, E.M.; Chapman, M.W. Morbidity at bone graft donor sites. J. Orthop. Trauma. 1989, 3, 192–195. [Google Scholar] [CrossRef]
- Diogo, G.S.; Permuy, M.; Marques, C.F.; Sotelo, C.G.; Pérez-Martín, R.I.; Serra, J.; González, P.; Munõz, F.; Pirraco, R.P.; Reis, R.L.; et al. In vivo assessment of marine vs bovine origin collagen-based composite scaffolds promoting bone regeneration in a New Zealand rabbit model. Biomater. Adv. 2024, 159, 213813. [Google Scholar] [CrossRef]
- Ottenbacher, N.; Alkildani, S.; Korzinskas, T.; Pissarek, J.; Ulm, C.; Jung, O.; Sundag, B.; Bellmann, O.; Stojanovic, S.; Najman, S.; et al. Novel Histomorphometrical Approach to Evaluate the Integration Pattern and Functionality of Barrier Membranes. Dent. J. 2021, 9, 127. [Google Scholar] [CrossRef]
- Liu, Y.; Guo, L.; Li, X.; Liu, S.; Du, J.; Xu, J.; Hu, J.; Liu, Y. Challenges and Tissue Engineering Strategies of Periodontal-Guided Tissue Regeneration. Tissue Eng. Part C Methods 2022, 28, 405–419. [Google Scholar] [CrossRef] [PubMed]
- Polimeni, G.; Koo, K.; Qahash, M.; Xiropaidis, A.V.; Albandar, J.M.; Wikesjö, U.M.E. Prognostic factors for alveolar regeneration: Effect of a space-providing biomaterial on guided tissue regeneration. J. Clin. Periodontol. 2004, 31, 725–729. [Google Scholar] [CrossRef]
- Hämmerle, C.H.F.; Jung, R.E. Bone augmentation by means of barrier membranes. Periodontology 2000 2003, 33, 36–53. [Google Scholar] [CrossRef] [PubMed]
- Bunyaratavej, P.; Wang, H. Collagen Membranes: A Review. J. Periodontol. 2001, 72, 215–229. [Google Scholar] [CrossRef] [PubMed]
- Friedl, P.; Wolf, K. Plasticity of cell migration: A multiscale tuning model. J. Cell Biol. 2010, 188, 11–19. [Google Scholar] [CrossRef] [PubMed]
- Thoma, D.S.; Bienz, S.P.; Figuero, E.; Jung, R.E.; Sanz-Martín, I. Efficacy of lateral bone augmentation performed simultaneously with dental implant placement: A systematic review and meta-analysis. J. Clin. Periodontol. 2019, 46, 257–276. [Google Scholar] [CrossRef]
- Chu, C.; Wang, Y.; Wang, Y.; Yang, R.; Liu, L.; Rung, S.; Xiang, L.; Wu, Y.; Du, S.; Man, Y.; et al. Evaluation of epigallocatechin-3-gallate (EGCG) modified collagen in guided bone regeneration (GBR) surgery and modulation of macrophage phenotype. Mater. Sci. Eng. C 2019, 99, 73–82. [Google Scholar] [CrossRef] [PubMed]
- Zhao, D.; Dong, H.; Niu, Y.; Fan, W.; Jiang, M.; Li, K.; Wei, Q.; Palin, W.M.; Zhang, Z. Electrophoretic deposition of novel semi-permeable coatings on 3D-printed Ti-Nb alloy meshes for guided alveolar bone regeneration. Dent. Mater. 2022, 38, 431–443. [Google Scholar] [CrossRef] [PubMed]
- Sbricoli, L.; Guazzo, R.; Annunziata, M.; Gobbato, L.; Bressan, E.; Nastri, L. Selection of Collagen Membranes for Bone Regeneration: A Literature Review. Materials 2020, 13, 786. [Google Scholar] [CrossRef]
- Shi, X.; Li, X.; Tian, Y.; Qu, X.; Zhai, S.; Liu, Y.; Jia, W.; Cui, Y.; Chu, S. Physical, mechanical, and biological properties of collagen membranes for guided bone regeneration: A comparative in vitro study. BMC Oral Health 2023, 23, 510. [Google Scholar] [CrossRef] [PubMed]
- Benic, G.I.; Hämmerle, C.H.F. Horizontal bone augmentation by means of guided bone regeneration. Periodontology 2000 2014, 66, 13–40. [Google Scholar] [CrossRef] [PubMed]
- Wu, D.T.; Jeffreys, N.; Diba, M.; Mooney, D.J. Viscoelastic Biomaterials for Tissue Regeneration. Tissue Eng. Part C Methods 2022, 28, 289–300. [Google Scholar] [CrossRef] [PubMed]
- Pelham, R.J.; Wang, Y. Cell locomotion and focal adhesions are regulated by substrate flexibility. Proc. Natl. Acad. Sci. USA 1997, 94, 13661–13665. [Google Scholar] [CrossRef]
- Engler, A.J.; Sen, S.; Sweeney, H.L.; Discher, D.E. Matrix Elasticity Directs Stem Cell Lineage Specification. Cell 2006, 126, 677–689. [Google Scholar] [CrossRef]
- Chaudhuri, O.; Cooper-White, J.; Janmey, P.A.; Mooney, D.J.; Shenoy, V.B. Effects of extracellular matrix viscoelasticity on cellular behaviour. Nature 2020, 584, 535–546. [Google Scholar] [CrossRef] [PubMed]
- Coïc, M.; Placet, V.; Jacquet, E.; Meyer, C. Propriétés mécaniques des membranes de collagène. Rev. Stomatol. Chir. Maxillo Faciale 2010, 111, 286–290. [Google Scholar] [CrossRef] [PubMed]
- Raz, P.; Brosh, T.; Ronen, G.; Tal, H. Tensile Properties of Three Selected Collagen Membranes. BioMed Res. Int. 2019, 2019, 5163603. [Google Scholar] [CrossRef] [PubMed]
- Zhang, M.; Zhou, Z.; Yun, J.; Liu, R.; Li, J.; Chen, Y.; Cai, H.; Jiang, H.B.; Lee, E.-S.; Han, J.; et al. Effect of Different Membranes on Vertical Bone Regeneration: A Systematic Review and Network Meta-Analysis. BioMed Res. Int. 2022, 2022, 7742687. [Google Scholar] [CrossRef] [PubMed]
- Wang, Q.; Zhou, F.; Qiu, T.; Liu, Y.; Luo, W.; Wang, Z.; Li, H.; Xiao, E.; Wei, Q.; Wu, Y. Scalable fabrication of porous membrane incorporating human extracellular matrix-like collagen for guided bone regeneration. J. Mater. Chem. B 2024, 12, 11142–11155. [Google Scholar] [CrossRef]
- Lu, S.; Wang, P.; Zhang, F.; Zhou, X.; Zuo, B.; You, X.; Gao, Y.; Liu, H.; Tang, H. A novel silk fibroin nanofibrous membrane for guided bone regeneration: A study in rat calvarial defects. Am. J. Transl. Res. 2015, 7, 2244–2253. [Google Scholar]
- Torres-Mansilla, A.; Hincke, M.; Voltes, A.; López-Ruiz, E.; Baldión, P.A.; Marchal, J.A.; Álvarez-Lloret, P.; Gómez-Morales, J. Eggshell Membrane as a Biomaterial for Bone Regeneration. Polymers 2023, 15, 1342. [Google Scholar] [CrossRef]
- Hussain, S.H.; Limthongkul, B.; Humphreys, T.R. The Biomechanical Properties of the Skin. Dermatol. Surg. 2013, 39, 193–203. [Google Scholar] [CrossRef]
- Glowacki, J.; Mizuno, S. Collagen scaffolds for tissue engineering. Biopolymers 2008, 89, 338–344. [Google Scholar] [CrossRef] [PubMed]
- Zellin, G. Effects of different osteopromotive membrane porosities on experimental bone neogenesis in rats. Biomaterials 1996, 17, 695–702. [Google Scholar] [CrossRef] [PubMed]
- Stübinger, S.; Dard, M. The Rabbit as Experimental Model for Research in Implant Dentistry and Related Tissue Regeneration. J. Investig. Surg. 2013, 26, 266–282. [Google Scholar] [CrossRef] [PubMed]
- Shah, S.R.; Young, S.; Goldman, J.L.; Jansen, J.A.; Wong, M.E.; Mikos, A.G. A composite critical-size rabbit mandibular defect for evaluation of craniofacial tissue regeneration. Nat. Protoc. 2016, 11, 1989–2009. [Google Scholar] [CrossRef] [PubMed]
- Desnica, J.; Vujovic, S.; Stanisic, D.; Ognjanovic, I.; Jovicic, B.; Stevanovic, M.; Rosic, G. Preclinical Evaluation of Bioactive Scaffolds for the Treatment of Mandibular Critical-Sized Bone Defects: A Systematic Review. Appl. Sci. 2023, 13, 4668. [Google Scholar] [CrossRef]
- Staedt, H.; Dau, M.; Schiegnitz, E.; Thiem, D.G.E.; Tagadiuc, O.; Palarie, V.; Ottl, P.; Al-Nawas, B.; Kämmerer, P.W. A collagen membrane influences bone turnover marker in vivo after bone augmentation with xenogenic bone. Head Face Med. 2020, 16, 35. [Google Scholar] [CrossRef]
- Owens, K.W.; Yukna, R.A. Collagen membrane resorption in dogs: A comparative study. Implant Dent. 2001, 10, 49–58. [Google Scholar] [CrossRef] [PubMed]

| ID | Batch 1 | Batch 2 | Batch 3 | Batch 4 | ||||
|---|---|---|---|---|---|---|---|---|
| Excess | Specimen | Excess | Specimen | Excess | Specimen | Excess | Specimen | |
| Measurements [µm] | 31.7 | 42.7 | 23.3 | 41.6 | 40.1 | 42.9 | 20.5 | 21.1 |
| 29.4 | 42.4 | 24.8 | 44.7 | 42.9 | 44.0 | 20.0 | 21.1 | |
| 27.8 | 42.7 | 23.5 | 45.1 | 39.0 | 42.7 | 20.0 | 21.1 | |
| 29.6 | 42.7 | 23.2 | 45.4 | 37.7 | 42.9 | 20.0 | 20.5 | |
| 30.9 | 42.1 | 23.2 | 43.1 | 36.6 | 41.3 | 19.7 | 22.7 | |
| 28.7 | 40.5 | 22.1 | 45.8 | 52.3 | 41.1 | 16.0 | 23.0 | |
| 30.1 | 40.3 | 21.9 | 44.6 | 46.0 | 41.4 | 18.0 | 23.0 | |
| 28.8 | 41.1 | 22.4 | 44.0 | 45.2 | 39.0 | 17.7 | 22.5 | |
| 28.5 | 41.3 | 21.9 | 44.9 | 42.7 | 38.1 | 16.1 | 21.9 | |
| 28.0 | 41.3 | 20.5 | 45.4 | 38.4 | 37.6 | 13.7 | 21.6 | |
| Mean [µm] | 29.4 | 41.7 | 22.7 | 44.5 | 42.1 | 41.1 | 18.2 | 21.9 |
| Deviation [µm] | 1.2 | 0.9 | 1.1 | 1.2 | 4.5 | 2.1 | 2.2 | 0.9 |
| L1a | L1b | L2a | L2b | L3a | L3b | L4a | L4b | L4c | |
|---|---|---|---|---|---|---|---|---|---|
| E [GPa] | 2.77 | 2.22 | 2.58 | 2.84 | 2.34 | 2.65 | 2.91 | 2.74 | 2.85 |
| σu [MPa] | 71.7 | 57.8 | 66.9 | 80 | 53.3 | 66.4 | 73.5 | 29.1 | 20.1 |
| Mean | Deviation | |
|---|---|---|
| E [GPa] | 2.56 | 0.24 |
| σu [MPa] | 65.43 | 9.57 |
| n | Mean | Std. Deviation | 95% Confidence Interval for Mean | p-Value | |||
|---|---|---|---|---|---|---|---|
| Lower Bound | Upper Bound | ||||||
| Mean BMD | Native bone | 4 | 1.11 | 0.10 | 0.94 | 1.28 | <0.05 |
| Cortical bone | 4 | 0.99 | 0.09 | 0.83 | 1.14 | ||
| Trabecular bone | 4 | 0.23 | 0.10 | 0.06 | 0.39 | ||
| BV/TV | Native bone | 4 | 70.22 | 4.72 | 62.70 | 77.74 | <0.05 |
| Cortical bone | 4 | 70.00 | 11.55 | 51.60 | 88.39 | ||
| Trabecular bone | 4 | 8.23 | 5.38 | −0.32 | 16.80 | ||
| Tb.Th | Native bone | 4 | 0.11 | 0.01 | 0.09 | 0.14 | n.s |
| Cortical bone | 4 | 0.14 | 0.03 | 0.08 | 0.20 | ||
| Trabecular bone | 4 | 0.10 | 0.01 | 0.08 | 0.12 | ||
| Tb.Sp | Native bone | 4 | 0.08 | 0.01 | 0.06 | 0.10 | <0.05 |
| Cortical bone | 4 | 0.11 | 0.02 | 0.07 | 0.15 | ||
| Trabecular bone | 4 | 1.33 | 0.87 | −0.05 | 2.73 | ||
| Tb.N | Native bone | 4 | 6.04 | 0.36 | 5.45 | 6.62 | <0.05 |
| Cortical bone | 4 | 5.09 | 0.74 | 3.91 | 6.27 | ||
| Trabecular bone | 4 | 0.80 | 0.48 | 0.03 | 1.57 | ||
Disclaimer/Publisher’s Note: The statements, opinions and data contained in all publications are solely those of the individual author(s) and contributor(s) and not of MDPI and/or the editor(s). MDPI and/or the editor(s) disclaim responsibility for any injury to people or property resulting from any ideas, methods, instructions or products referred to in the content. |
© 2025 by the authors. Licensee MDPI, Basel, Switzerland. This article is an open access article distributed under the terms and conditions of the Creative Commons Attribution (CC BY) license (https://creativecommons.org/licenses/by/4.0/).
Share and Cite
Gallego, L.; Harvey, K.; Pevida, M.; García-Consuegra, L.; García-Suárez, O.; Meana, Á.; Alvarez-Viejo, M.; Junquera, L. From Waste to Innovation: A Circular Economy Approach for Tissue Engineering by Transforming Human Bone Waste into Novel Collagen Membranes. Biomolecules 2025, 15, 132. https://doi.org/10.3390/biom15010132
Gallego L, Harvey K, Pevida M, García-Consuegra L, García-Suárez O, Meana Á, Alvarez-Viejo M, Junquera L. From Waste to Innovation: A Circular Economy Approach for Tissue Engineering by Transforming Human Bone Waste into Novel Collagen Membranes. Biomolecules. 2025; 15(1):132. https://doi.org/10.3390/biom15010132
Chicago/Turabian StyleGallego, Lorena, Kimberly Harvey, Marta Pevida, Luis García-Consuegra, Olivia García-Suárez, Álvaro Meana, María Alvarez-Viejo, and Luis Junquera. 2025. "From Waste to Innovation: A Circular Economy Approach for Tissue Engineering by Transforming Human Bone Waste into Novel Collagen Membranes" Biomolecules 15, no. 1: 132. https://doi.org/10.3390/biom15010132
APA StyleGallego, L., Harvey, K., Pevida, M., García-Consuegra, L., García-Suárez, O., Meana, Á., Alvarez-Viejo, M., & Junquera, L. (2025). From Waste to Innovation: A Circular Economy Approach for Tissue Engineering by Transforming Human Bone Waste into Novel Collagen Membranes. Biomolecules, 15(1), 132. https://doi.org/10.3390/biom15010132

